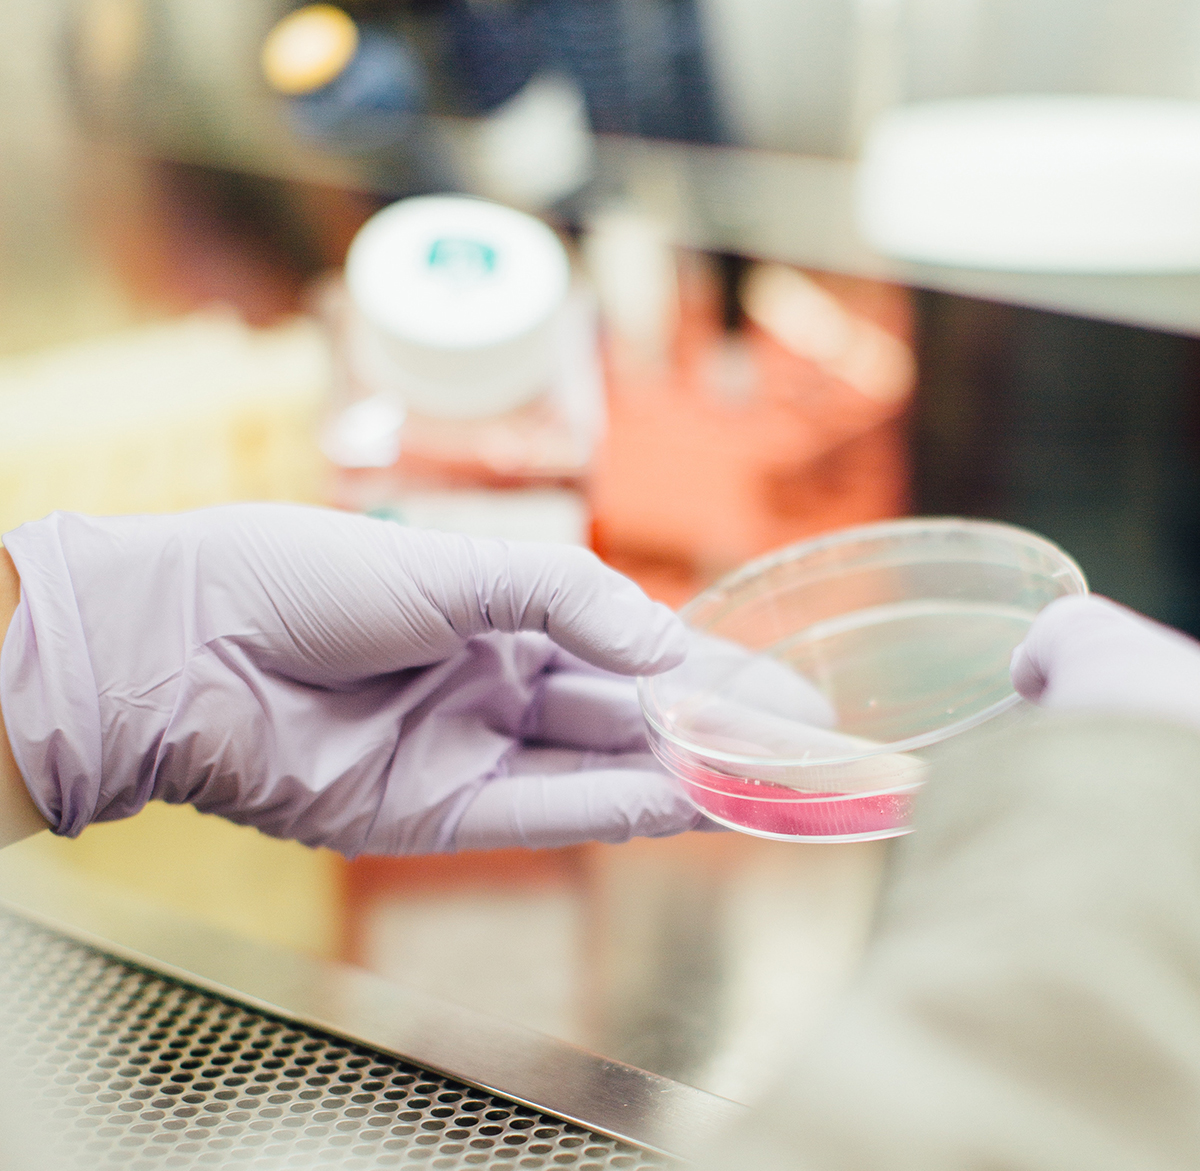
RASFF analisi

Bento Box: una buona abitudine in pausa pranzo
La Bento Box è una buona abitudine alimentare che ci arriva da lontano, precisamente dal Giappone. Ma esattamente cos’è? Se volessimo spiegarla in parole povere potremmo semplicemente dire pranzo al sacco, ma sarebbe riduttivo: dietro la tradizionale Bento Box c’è molto di più. In Giappone, sin da piccoli, i bambini vengono abituati a portarsi il…
Leggi tutto